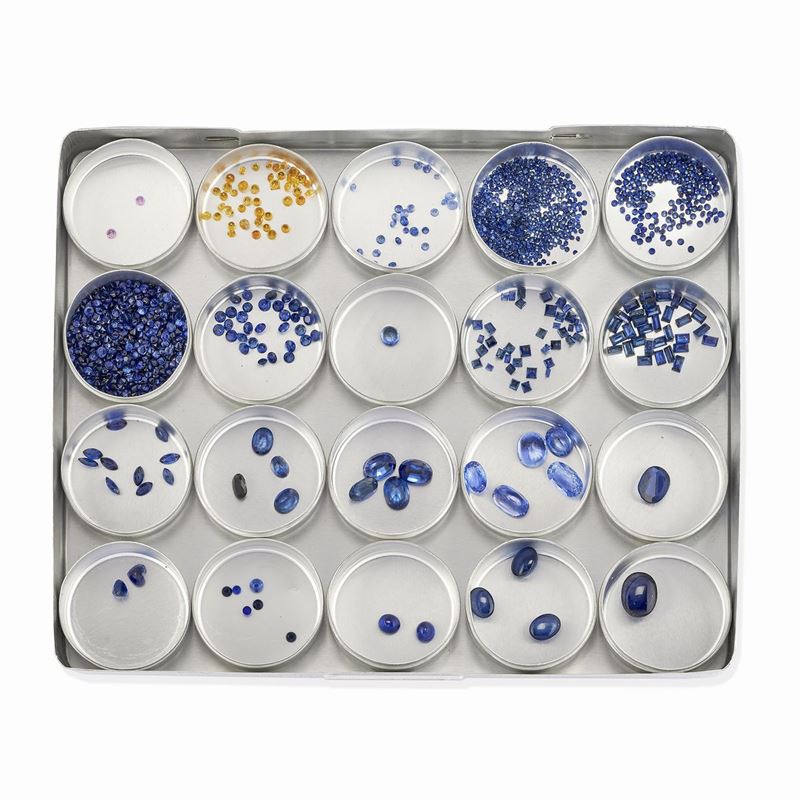

643
Cofanetto con zaffiri, blu, gialli e rosa, ct 94,95
di tagli diversi per totale ct 94,95 suddivisi in venti scatolette: colore rosa taglio brillante ct 0,14, colore giallo taglio brillante ct 2,61, blu: taglio brillante ct 40,37, taglio carré ct 3,19, taglio rettangolare ct 6,14, taglio marquise ct 2,07, taglio ovale ct 24,38, taglio cuore ct 1,42, taglio tondo cabochon ct 0,61, taglio ovale cabochon ct 14,02.
Totale ct 94,95
Base d'asta
€ 3.000
Lotto venduto
€ 1.600
I prezzi di vendita comprendono i diritti d'asta
Hai un lotto simile a questo che vorresti vendere?
Informazioni
Contatta il dipartimento
Lotti suggeriti
Caricamento lotti suggeriti...